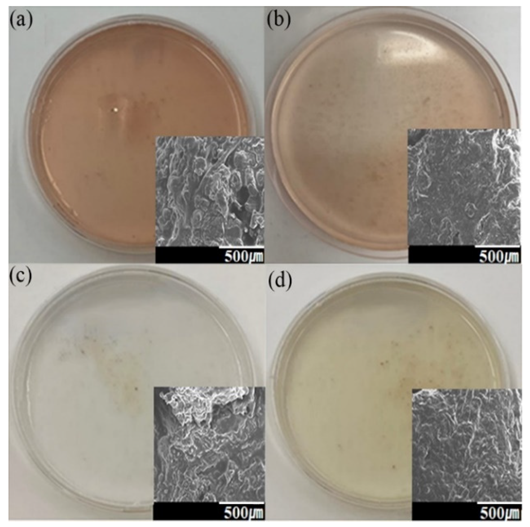
Foods 11 00554 g004

3D Printing of Meat Following Supercritical Fluid Extraction
Abstract
1. Introduction
2. Materials and Methods
2.1. Meat Preparation
2.2. SCF Extraction
2.3. 3D Printing of Meat
3. Results and Discussion
4. Conclusions
Author Contributions
Funding
Institutional Review Board Statement
Informed Consent Statement
Data Availability Statement
Conflicts of Interest
References
- Hunt, M.; Sorheim, O.; Slinde, E. Color and Heat Denaturation of Myoglobin Forms in Ground Beef. J. Food Sci. 1999, 64, 847–851. [Google Scholar] [CrossRef]
- FAO. Food Handlers Manual Instructor. 2017. Available online: http://www.fao.org/3/a-i5896e.pdf (accessed on 1 March 2021).
- Ab Talib, M.S.; Sawari, S.S.M.; Hamid, A.B.A.; Chin, T.A. Emerging Halal food market: An Institutional Theory of Halal certificate implementation. Manag. Res. Rev. 2016, 39, 987–997. [Google Scholar] [CrossRef]
- Mumuni, A.G.; Veeck, A.; Luqmani, M.; Quraeshi, Z.A.; Kamarulzaman, Y. Religious identity, community and religious minorities’ search efforts for religiously sanctioned food: The case of halal food in non-Muslim majority markets. Int. J. Consum. Stud. 2018, 42, 586–598. [Google Scholar] [CrossRef]
- Aziz, Y.A.; Chok, N.V. The Role of Halal Awareness, Halal Certification, and Marketing Components in Determining Halal Purchase Intention Among Non-Muslims in Malaysia: A Structural Equation Modeling Approach. J. Int. Food Agribus. Mark. 2013, 25, 1–23. [Google Scholar] [CrossRef]
- Yang, F.; Zhang, M.; Bhandari, B. Recent development in 3D food printing. Crit. Rev. Food Sci. Nutr. 2017, 57, 3145–3153. [Google Scholar] [CrossRef]
- Kim, N.; Eo, J.; Cepeda, B.; Kim, J. A New Paradigm of Pharmaceutical Drug Delivery Systems (DDS): Challenges for Space, Time, and Shapes. Innov. Pharm. 2018, 9, 11. [Google Scholar] [CrossRef]
- Adamek, J. Halal food market vs. Polish meat producers. On the dissimilarities in approaching the idea of sustainable development. Pr. Nauk. Uniw. Ekon. We Wrocławiu 2015, 397, 9–19. [Google Scholar] [CrossRef]
- Riaz, M.N.; Chaudry, M.M. Halal Food Production; CRC Press: Boca Raton, FL, USA, 2003. [Google Scholar]
- Zailani, S.; Arrifin, Z.; Wahid, N.A.; Othman, R.; Fernando, Y. Halal Traceability and Halal Tracking Systems in Strengthening Halal Food Supply Chain for Food Industry in Malaysia (A Review). J. Food Technol. 2010, 8, 74–81. [Google Scholar] [CrossRef]
- Nakyinsige, K.; Fatimah, A.B.; Aghwan, Z.A.; Zulkifli, I.; Goh, Y.M.; Sazili, A.Q. Bleeding Efficiency and Meat Oxidative Stability and Microbiological Quality of New Zealand White Rabbits Subjected to Halal Slaughter without Stunning and Gas Stun-killing. Asian-Australas. J. Anim. Sci. 2014, 27, 406–413. [Google Scholar] [CrossRef]
- Alvarado, C.; McKee, S. Marination to Improve Functional Properties and Safety of Poultry Meat. J. Appl. Poult. Res. 2007, 16, 113–120. [Google Scholar] [CrossRef]
- Leal-Ramos, M.Y.; Alarcon-Rojo, A.D.; Mason, T.J.; Paniwnyk, L.; Alarjah, M. Ultrasound-enhanced mass transfer in Halal compared with non-Halal chicken. J. Sci. Food Agric. 2011, 91, 130–133. [Google Scholar] [CrossRef] [PubMed]
- Sărăcin, V.C. The Halal Food Law in Malaysia. Contemp. Read. Law Soc. Justice 2017, 9, 372–382. [Google Scholar]
- Ismail, A.G.; Ali, M.; Noor, M. Halal Finance and Halal Foods: Are They Falling Apart ? Economica 2016, 12, 113–126. [Google Scholar]
- Johan, E. New challenges in asean regional market: International trade framework on halal standard. J. Din. Huk. 2018, 18, 93–102. [Google Scholar] [CrossRef][Green Version]
- Baiano, A. Recovery of Biomolecules from Food Wastes—A Review. Molecules 2014, 19, 14821–14842. [Google Scholar] [CrossRef]
- Ashraf-Khorassani, M.; Gidanian, S.; Yamini, Y. Effect of Pressure, Temperature, Modifier, Modifier Concentration, and Sample Matrix on the Supercritical Fluid Extraction Efficiency of Different Phenolic Compounds. J. Chromatogr. Sci. 1995, 33, 658–662. [Google Scholar] [CrossRef]
- Ali-Nehari, A.; Kim, S.-B.; Lee, Y.-B.; Chun, B.-S. Digestive enzymes characterization of krill (Euphausia superba) residues deoiled by supercritical carbon dioxide and organic solvents. J. Ind. Eng. Chem. 2012, 18, 1314–1319. [Google Scholar] [CrossRef]
- Chung, S.; Kwon, H.; Kim, N.P. Supercritical extraction of decellularized extracellular matrix from porcine adipose tissue as regeneration therapeutics. J. Cosmet. Med. 2019, 3, 86–93. [Google Scholar] [CrossRef]
- Roy, B.C.; Goto, M.; Hirose, T. Extraction of Ginger Oil with Supercritical Carbon Dioxide: Experiments and Modeling. Ind. Eng. Chem. Res. 1996, 35, 607–612. [Google Scholar] [CrossRef]
- Raventós, M.; Duarte, S.; Alarcón, R. Application and Possibilities of Supercritical CO2 Extraction in Food Processing Industry: An Overview. Food Sci. Technol. Int. 2002, 8, 269–284. [Google Scholar] [CrossRef]
- Wehling, R.L.; Froning, G.W.; Cuppett, S.L.; Niemann, L. Extraction of cholesterol and other lipids from dehydrated beef using supercritical carbon dioxide. J. Agric. Food Chem. 1992, 40, 1204–1207. [Google Scholar] [CrossRef]
- Taylor-Black, S.; Wang, J. The prevalence and characteristics of food allergy in urban minority children. Ann. Allergy Asthma Immunol. 2012, 109, 431–437. [Google Scholar] [CrossRef]
- Liu, Z.; Zhang, M.; Bhandari, B.; Yang, C. Impact of rheological properties of mashed potatoes on 3D printing. J. Food Eng. 2018, 220, 76–82. [Google Scholar] [CrossRef]
- Kim, N.S.; Han, K.N.; Church, K.H. Direct Writing Technology for 21st Century Industries-Focus on Micro-Dispensing Deposition Write Technology. J. KSMTE 2007, 5, 511–515. [Google Scholar]
- Kim, N.P.; Cho, D.; Zielewski, M. Optimization of 3D printing parameters of Screw Type Extrusion (STE) for ceramics using the Taguchi method. Ceram. Int. 2019, 45, 2351–2360. [Google Scholar] [CrossRef]
- Le Tohic, C.; O’Sullivan, J.; Drapala, K.P.; Chartrin, V.; Chan, T.; Morrison, A.; Kerry, J.P.; Kelly, A.L. Effect of 3D printing on the structure and textural properties of processed cheese. J. Food Eng. 2018, 220, 56–64. [Google Scholar] [CrossRef]
- Dick, A.; Bhandari, B.; Prakash, S. 3D printing of meat. Meat Sci. 2019, 153, 35–44. [Google Scholar] [CrossRef]
- Değerli, C. Processed Meat Production in 3 Dimensional (3D) Printing Technology. Turk. J. Agric.-Food Sci. Technol. 2020, 8, 1018–1026. [Google Scholar]
- Portanguen, S.; Tournayre, P.; Sicard, J.; Astruc, T.; Mirade, P.-S. Toward the design of functional foods and biobased products by 3D printing: A review. Trends Food Sci. Technol. 2019, 86, 188–198. [Google Scholar] [CrossRef]
- Godoi, F.C.; Prakash, S.; Bhandari, B.R. 3d printing technologies applied for food design: Status and prospects. J. Food Eng. 2016, 179, 44–54. [Google Scholar] [CrossRef]
- Kim, N.P.; Eo, J.-S.; Cho, D. Optimization of piston type extrusion (PTE) techniques for 3D printed food. J. Food Eng. 2018, 235, 41–49. [Google Scholar] [CrossRef]
- Hoffman, J.; Hwang, S.; Ortega, A.; Kim, N.P.; Moon, K.-S. The Standardization of Printable Materials and Direct Writing Systems. J. Electron. Packag. 2013, 135, 011006. [Google Scholar] [CrossRef]
- Hong, S.; Kim, N. Synthesis of 3D Printable Cu–Ag Core–Shell Materials: Kinetics of CuO Film Removal. J. Electron. Mater. 2015, 44, 823–830. [Google Scholar] [CrossRef]

| Materials | Treatment Method | Extracted Ingredients |
|---|---|---|
| Vegetables | Temperature range of 35–65 °C and pressure of 4.05 × 107 Pa. Hexane or chloroform as co-solvent. | Extracted carotene from carrots, sweet potatoes, paprika, and tomato paste. |
| Dairy products | Temperature range of 60–80 °C and pressure of 3.70 × 107~5.47 × 107 Pa. Methanol or ethanol as co-solvents. | Extracted vitamin A and E from cow milk and removing fat. |
| Eucalyptus leaves | A temperature of 50 °C and pressure of 2.03 × 107 Pa | Extracted plant oil |
| Coffee beans | A temperature of 90 °C and pressure range of 1.60 × 107~2.20 × 107 Pa. Water as co-solvent. | Decaffeination of green coffee beans |
| Wine and beer | Temperature range of 25–40 °C and pressure range of 7.60 × 106~3.00 × 107 Pa. | Decreased alcohol concentration |
| SCF Time (min) | Extraction Temperature (°C) | Pressure × 107 (Pa) | Co-Solvent |
|---|---|---|---|
| 40 | 35 ± 5 | 2.03 | - |
| 3.04 | - | ||
| 4.05 | - | ||
| 50 ± 5 | 2.03 | - | |
| 3.04 | - | ||
| 4.05 | - | ||
| 50 ± 5 | 3.04 | Water | |
| 4.05 | Water | ||
| 3.04 | Vegetable oil | ||
| 4.05 | Vegetable oil |
| Velocity of Press (m/s) | Tip Size (m) | Shear Rate (1/s) | ∆PFriction (Pa) | STDEV of ∆PFriction | ∆PTip (Pa) | STDEV of ∆PTip | ∆PPiston (Pa) | qv (m3/s) | STDEV of qv | |
| Air | 8.33 × 10−5 | 4.00 × 10−4 | 2.99 × 102 | 2.39 × 104 | 1.83 × 103 | 4.06 × 10−1 | 2.20 × 10−1 | 1.47 × 10−5 | 1.50 × 10−8 | 8.16 × 10−9 |
| 8.33 × 10−5 | 2.00 × 10−4 | 2.34 × 103 | 2.67 × 104 | 2.32 × 103 | 6.39 × 100 | 2.69 × 100 | 1.44 × 10−5 | 1.47 × 10−8 | 6.22 × 10−9 | |
| 8.33 × 10−5 | 1.10 × 10−4 | 1.43 × 104 | 2.88 × 104 | 2.60 × 103 | 7.04 × 101 | 3.37 × 101 | 1.45 × 10−5 | 1.49 × 10−8 | 7.13 × 10−9 | |
| 8.33 × 10−5 | 7.50 × 10−5 | 4.49 × 104 | 3.04 × 104 | 1.41 × 103 | 3.25 × 102 | 1.49 × 102 | 1.45 × 10−5 | 1.49 × 10−8 | 6.81 × 10−9 | |
| 1.67 × 10−4 | 7.50 × 10−4 | 2.94 × 102 | 4.19 × 104 | None | 2.13 × 10−1 | None | 9.47 × 10−5 | 9.73 × 10−8 | None | |
| 3.33 × 10−4 | 7.50 × 10−4 | 5.81 × 102 | 3.62 × 104 | None | 4.21 × 10−1 | None | 1.88 × 10−4 | 1.93 × 10−7 | None | |
| 5.00 × 10−4 | 7.50 × 10−4 | 8.72 × 102 | 2.98 × 104 | None | 6.31 × 10−1 | None | 2.81 × 10−4 | 2.89 × 10−7 | None | |
| 6.67 × 10−4 | 7.50 × 10−4 | 1.14 × 103 | 1.99 × 104 | None | 8.26 × 10−1 | None | 3.68 × 10−4 | 3.78 × 10−7 | None | |
| 8.33 × 10−4 | 1.00 × 10−3 | 1.90 × 101 | 1.55 × 104 | 9.20 × 102 | 1.03 × 10−2 | 1.03 × 10−2 | 1.46 × 10−5 | 1.49 × 10−7 | 7.40 × 10−9 | |
| 8.33 × 10−4 | 7.50 × 10−4 | 4.52 × 101 | 2.07 × 104 | 1.41 × 103 | 3.27 × 10−2 | 1.63 × 10−2 | 1.46 × 10−5 | 1.50 × 10−7 | 7.44 × 10−9 | |
| 8.33 × 10−4 | 1.00 × 10−3 | 1.83 × 102 | 1.44 × 104 | 1.85 × 103 | 9.93 × 10−2 | 7.58 × 10−3 | 1.40 × 10−4 | 1.44 × 10−7 | 1.10 × 10−8 | |
| 8.33 × 10−4 | 7.50 × 10−4 | 4.32 × 102 | 2.08 × 104 | 1.30 × 103 | 3.13 × 10−1 | 2.32 × 10−2 | 1.40 × 10−4 | 1.43 × 10−7 | 1.06 × 10−8 | |
| 8.33 × 10−4 | 7.50 × 10−4 | 1.41 × 102 | 1.90 × 104 | None | 1.02 × 100 | None | 4.56 × 10−4 | 4.68 × 10−7 | None | |
| 8.33 × 10−4 | 4.00 × 10−4 | 2.86 × 103 | 2.13 × 104 | 1.35 × 103 | 3.88 × 100 | 3.17 × 10−1 | 1.40 × 10−4 | 1.44 × 10−7 | 1.17 × 10−8 | |
| 8.33 × 10−4 | 2.00 × 10−4 | 2.28 × 104 | 2.50 × 104 | 1.58 × 103 | 6.20 × 101 | 4.91 × 100 | 1.40 × 10−4 | 1.44 × 10−7 | 1.14 × 10−8 | |
| 8.33 × 10−4 | 1.10 × 10−4 | 1.38 × 105 | 2.90 × 104 | 1.92 × 103 | 6.80 × 102 | 6.15 × 101 | 1.40 × 10−4 | 1.44 × 10−7 | 1.30 × 10−8 | |
| 1.67 × 10−4 | 7.50 × 10−4 | 8.58 × 102 | 2.96 × 104 | 1.28 × 103 | 1.00 × 100 | 0.00 × 100 | 2.77 × 10−4 | 2.84 × 10−7 | 9.92 × 10−9 | |
| 1.67 × 10−3 | 4.00 × 10−4 | 5.66 × 103 | 2.94 × 104 | 8.92 × 102 | 8.00 × 100 | 0.00 × 100 | 2.77 × 10−4 | 2.84 × 10−7 | 1.01 × 10−8 | |
| 1.67 × 10−3 | 2.00 × 10−4 | 4.51 × 104 | 2.61 × 104 | 1.40 × 103 | 1.23 × 102 | 4.00 × 100 | 2.76 × 10−4 | 2.83 × 10−7 | 8.83 × 10−9 | |
| 1.67 × 10−3 | 1.10 × 10−4 | 2.75 × 105 | 3.41 × 104 | 1.16 × 103 | 1.36 × 103 | 5.40 × 101 | 2.80 × 10−4 | 2.87 × 10−7 | 1.14 × 10−8 | |
| 3.33 × 10−3 | 7.50 × 10−4 | 1.67 × 103 | 3.14 × 104 | 5.37 × 102 | 1.21 × 100 | 2.76 × 10−2 | 5.40 × 10−4 | 5.55 × 10−7 | 1.26 × 10−8 | |
| 3.33 × 10−3 | 4.00 × 10−4 | 1.10 × 104 | 3.47 × 104 | 9.43 × 102 | 1.49 × 101 | 4.43 × 10−1 | 5.38 × 10−4 | 5.53 × 10−7 | 1.64 × 10−8 | |
| 3.33 × 10−3 | 2.00 × 10−4 | 8.83 × 104 | 3.31 × 104 | 5.14 × 102 | 2.40 × 102 | 5.68 × 100 | 5.40 × 10−4 | 5.55 × 10−7 | 1.31 × 10−8 | |
| 3.33 × 10−3 | 1.10 × 10−4 | 5.33 × 105 | 4.49 × 104 | 8.73 × 103 | 2.63 × 103 | 4.58 × 101 | 5.42 × 10−4 | 5.57 × 10−7 | 9.70 × 10−9 | |
| Water | 8.33 × 10−5 | 2.00 × 10−4 | 2.37 × 103 | 4.83 × 103 | 3.10 × 102 | 3.17 × 102 | 1.06 × 101 | 6.41 × 10−4 | 1.49 × 10−8 | 4.99 × 10−10 |
| 8.33 × 10−5 | 4.00 × 10−4 | 2.95 × 102 | 5.76 × 103 | 1.01 × 103 | 1.91 × 101 | 3.23 × 100 | 6.36 × 10−4 | 1.48 × 10−8 | 2.18 × 10−10 | |
| 8.33 × 10−5 | 7.50 × 10−4 | 4.56 × 101 | 4.89 × 103 | 4.15 × 102 | 1.62 × 100 | 1.15 × 10−1 | 6.49 × 10−4 | 1.51 × 10−8 | 1.07 × 10−9 | |
| 8.33 × 10−5 | 1.00 × 10−3 | 1.92 × 101 | 6.08 × 103 | 4.06 × 102 | 5.13 × 10−1 | 5.13 × 10−1 | 6.49 × 10−4 | 1.51 × 10−8 | 1.05 × 10−9 | |
| 8.33 × 10−4 | 2.00 × 10−4 | 2.17 × 104 | 1.09 × 103 | 9.20 × 102 | 2.89 × 103 | 1.74 × 102 | 6.52 × 10−4 | 1.37 × 10−7 | 8.19 × 10−9 | |
| 8.33 × 10−4 | 4.00 × 10−4 | 2.72 × 103 | 8.19 × 103 | 1.64 × 103 | 1.76 × 102 | 3.13 × 101 | 6.54 × 10−3 | 1.36 × 10−7 | 7.63 × 10−9 | |
| 8.33 × 10−4 | 7.50 × 10−4 | 4.13 × 102 | 8.73 × 103 | 8.04 × 102 | 1.47 × 101 | 7.41 × 10−1 | 6.55 × 10−3 | 1.37 × 10−7 | 6.90 × 10−9 | |
| 8.33 × 10−4 | 1.00 × 10−3 | 1.74 × 102 | 8.45 × 103 | 9.85 × 102 | 4.64 × 100 | 4.64 × 100 | 6.53 × 10−3 | 1.36 × 10−7 | 7.83 × 10−9 | |
| 1.67 × 10−3 | 2.00 × 10−4 | 4.29 × 104 | 2.86 × 104 | 3.16 × 103 | 5.71 × 103 | 5.18 × 102 | 1.29 × 10−2 | 2.70 × 10−7 | 2.44 × 10−8 | |
| 1.67 × 10−3 | 4.00 × 10−4 | 5.37 × 103 | 1.16 × 104 | 2.43 × 103 | 3.46 × 102 | 7.30 × 101 | 1.29 × 10−2 | 2.70 × 10−7 | 2.14 × 10−8 | |
| 1.67 × 10−3 | 7.50 × 10−4 | 8.17 × 102 | 1.10 × 104 | 8.31 × 102 | 2.91 × 101 | 2.18 × 100 | 1.30 × 10−2 | 2.71 × 10−7 | 2.03 × 10−8 | |
| 1.67 × 10−3 | 1.00 × 10−3 | 3.45 × 102 | 1.04 × 104 | 1.14 × 103 | 9.22 × 100 | 9.22 × 100 | 1.30 × 10−2 | 2.71 × 10−7 | 1.92 × 10−8 | |
| 3.33 × 10−3 | 2.00 × 10−4 | 8.59 × 104 | 5.76 × 104 | 4.54 × 103 | 1.14 × 104 | 9.89 × 102 | 2.57 × 10−2 | 5.40 × 10−7 | 4.65 × 10−8 | |
| 3.33 × 10−3 | 4.00 × 10−4 | 1.07 × 104 | 2.10 × 104 | 2.93 × 103 | 7.12 × 102 | 6.38 × 101 | 2.57 × 10−2 | 5.37 × 10−7 | 4.80 × 10−8 | |
| 3.33 × 10−3 | 7.50 × 10−4 | 1.63 × 103 | 1.62 × 104 | 1.84 × 103 | 5.79 × 101 | 4.71 × 100 | 2.58 × 10−2 | 5.38 × 10−7 | 4.38 × 10−8 | |
| 3.33 × 10−3 | 1.00 × 10−3 | 6.83 × 102 | 1.69 × 104 | 2.21 × 103 | 1.82 × 101 | 1.82 × 101 | 2.57 × 10−2 | 5.36 × 10−7 | 4.64 × 10−8 |
Publisher’s Note: MDPI stays neutral with regard to jurisdictional claims in published maps and institutional affiliations. |
© 2022 by the authors. Licensee MDPI, Basel, Switzerland. This article is an open access article distributed under the terms and conditions of the Creative Commons Attribution (CC BY) license (https://creativecommons.org/licenses/by/4.0/).
Share and Cite
Aditya, A.; Kim, N.P. 3D Printing of Meat Following Supercritical Fluid Extraction. Foods 2022, 11, 554. https://doi.org/10.3390/foods11040554
Aditya A, Kim NP. 3D Printing of Meat Following Supercritical Fluid Extraction. Foods. 2022; 11(4):554. https://doi.org/10.3390/foods11040554
Chicago/Turabian StyleAditya, Abhilash, and Namsoo Peter Kim. 2022. "3D Printing of Meat Following Supercritical Fluid Extraction" Foods 11, no. 4: 554. https://doi.org/10.3390/foods11040554
APA StyleAditya, A., & Kim, N. P. (2022). 3D Printing of Meat Following Supercritical Fluid Extraction. Foods, 11(4), 554. https://doi.org/10.3390/foods11040554

